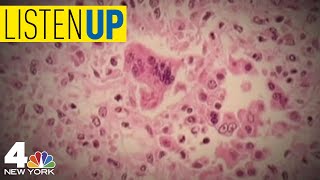

Summer Camp Is The Newest Front in Measles Outbreak Battle | Listen Up video
Online izle ve mp4 mp3 formatlarinda yukle

Videonun muddeti: 1:57
Summer Camp Is The Newest Front in Measles Outbreak Battle | Listen Up videosu mp4 ve mp3 yuklemek ucun hazirdir
Diqqet! Siz Mp4 yukle ve ya Mp3 yukle duymesine basdiqdan sonra eger sistem sizi reklam sehifesine atarsa o zaman derhal geri qayidib emeliyyati tekrar edin ve faylin yuklemek ucun hazir olmasini gozleyin
Videodan Mp4 Yukle
Videodan Mp3 Yukle-1
Videodan Mp3 Yukle-2
Oxshar Axtarishlar
 Summer Camp Is The Newest Front in Measles Outbreak Battle | Listen Up
Summer Camp Is The Newest Front in Measles Outbreak Battle | Listen Up Summer camps face new risk amid ongoing measles outbreak
Summer camps face new risk amid ongoing measles outbreak Measles Outbreak: Summer Camps Demanding Vaccinations, Summer Travel To Be Impacted By 'Do Not Board
Measles Outbreak: Summer Camps Demanding Vaccinations, Summer Travel To Be Impacted By 'Do Not Board Local summer camps watching measles outbreak
Local summer camps watching measles outbreak What's the latest on the measles outbreak?
What's the latest on the measles outbreak? Measles Outbreak Alert: Travel Safety Tips for Spring & Summer 2025
Measles Outbreak Alert: Travel Safety Tips for Spring & Summer 2025 Local summer camps watching measles outbreak
Local summer camps watching measles outbreak Summer camps in Mass are stressing the need for vaccinations
Summer camps in Mass are stressing the need for vaccinations Could children end up catching measles at a summer camp in Georgia?
Could children end up catching measles at a summer camp in Georgia?
Video Mp4 Mp3Azwap.Biz
Azwap.Biz 2021-2023

Summer Camp Is The Newest Front in Measles Outbreak Battle | Listen Up
Summer Camp Is The Newest Front in Measles Outbreak Battle | Listen Up Summer camps face new risk amid ongoing measles outbreak
Summer camps face new risk amid ongoing measles outbreak Measles Outbreak: Summer Camps Demanding Vaccinations, Summer Travel To Be Impacted By 'Do Not Board
Measles Outbreak: Summer Camps Demanding Vaccinations, Summer Travel To Be Impacted By 'Do Not Board Local summer camps watching measles outbreak
Local summer camps watching measles outbreak What's the latest on the measles outbreak?
What's the latest on the measles outbreak? Measles Outbreak Alert: Travel Safety Tips for Spring & Summer 2025
Measles Outbreak Alert: Travel Safety Tips for Spring & Summer 2025 Local summer camps watching measles outbreak
Local summer camps watching measles outbreak Summer camps in Mass are stressing the need for vaccinations
Summer camps in Mass are stressing the need for vaccinations Could children end up catching measles at a summer camp in Georgia?
Could children end up catching measles at a summer camp in Georgia?